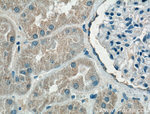
HDGF Antibody in Immunohistochemistry (Paraffin) (IHC (P))

Search
Proteintech
HDGF Monoclonal Antibody (5A7G3)
{{$productOrderCtrl.translations['antibody.pdp.commerceCard.promotion.promotions']}}
{{$productOrderCtrl.translations['antibody.pdp.commerceCard.promotion.viewpromo']}}
{{$productOrderCtrl.translations['antibody.pdp.commerceCard.promotion.promocode']}}: {{promo.promoCode}} {{promo.promoTitle}} {{promo.promoDescription}}. {{$productOrderCtrl.translations['antibody.pdp.commerceCard.promotion.learnmore']}}
产品信息
60064-1-IG
种属反应
已发表种属
宿主/亚型
分类
类型
克隆号
抗原
偶联物
形式
浓度
规格
纯化类型
保存液
内含物
保存条件
运输条件
产品详细信息
Immunogen sequence: MSRSNRQKE YKCGDLVFAK MKGYPHWPAR IDEMPEAAVK STANKYQVFF FGTHETAFLG PKDLFPYEES KEKFGKPNKR KGFSEGLWEI ENNPTVKASG YQSSQKKSCV EEPEPEPEAA EGDGDKKGNA EGSSDEEGKL VIDEPAKEKN EKGALKRRAG DLLEDSPKRP KEAENPEGEE KEAATLEVER PLPMEVEKNS TPSEPGSGRG PPQEEEEEED EEEEATKEDA EAPGIRDHES L (1-240 aa encoded by BC018991)
靶标信息
HDGF is a member of the hepatoma-derived growth factor family. This protein has mitogenic and DNA-binding activity and may play a role in cellular proliferation and differentiation.
仅用于科研。不用于诊断过程。未经明确授权不得转售。
生物信息学
蛋白别名: DKFZp686J1764; epididymis secretory sperm binding protein; FLJ96580; HDGF; hepatoma derived growth factor; Hepatoma-derived growth factor; High mobility group protein 1-like 2; HMG-1L2; unnamed protein product
基因别名: AI118077; D3Ertd299e; HDGF; HMG1L2; Tdrm1
UniProt ID: (Human) P51858, (Rat) Q8VHK7, (Mouse) P51859
Entrez Gene ID: (Human) 3068, (Rat) 114499, (Mouse) 15191